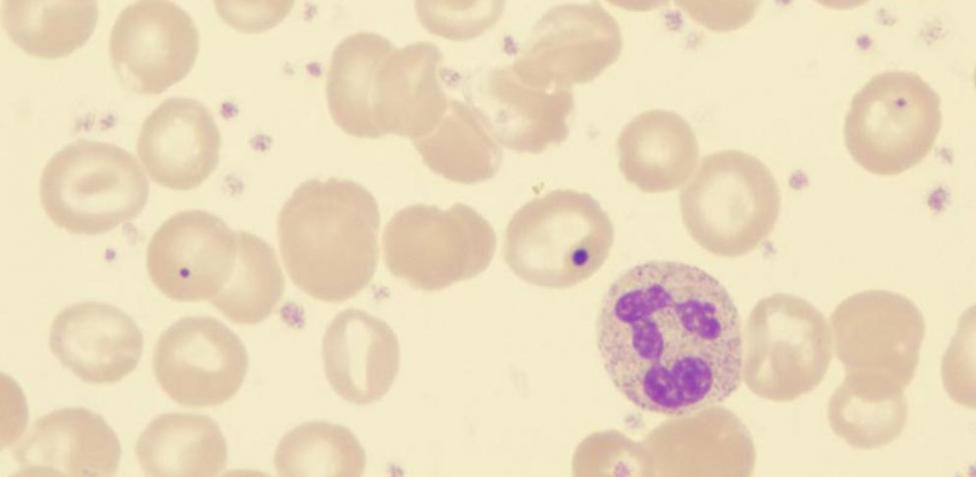

La trombocitosis. Las plaquetas son partículas de sangre que se producen en la médula ósea que desempeñan un papel importante en el proceso de formación de coágulos de sangre. La trombocitosis es un trastorno en el cual tu cuerpo produce demasiadas plaquetas.
Se denomina trombocitosis reactiva o trombocitosis secundaria cuando la causa es una condición oculta, como una infección.
Con menor frecuencia, cuando la trombocitosis no tiene un trastorno oculto como causa, el trastorno se denomina trombocitemia primaria o trombocitemia esencial. Esta es una enfermedad de la sangre y la médula ósea.
Tu médico podría detectar la trombocitosis en el resultado de un análisis de sangre de rutina que muestra un nivel alto de plaquetas. Si tu análisis de sangre indica trombocitosis, es importante determinar si es trombocitosis reactiva o trombocitemia esencial para saber cómo manejar el trastorno.
Son los fragmentos citoplasmáticos, irregulares y sin núcleo, que se encargan de la coagulación de la sangre que son producidos en la médula ósea por unas células llamadas megacariocitos. Un recuento normal de plaquetas en sangre se sitúa entre 150.000 y 450.000 plaquetas por micro litro de sangre, aunque una pequeña desviación por encima o por debajo de esta cifra no se considera significativo. Recuentos más allá de 750.000 son considerados límites.
Se calcula que la trombocitosis afecta aproximadamente a 2 o 3 personas de cada 100 000. El mayor número de caso se produce en personas mayores de 50 años y es más frecuente en las mujeres.
Causas de la trombocitosis
Producción excesiva de plaquetas
Hay dos tipos de trombocitosis, la reactiva y la esencial. La primera está causada por otra enfermedad como sangrado agudo, cáncer, infecciones, deficiencia de hierro, anemia hemolítica, trastornos inflamatorios como la artritis reumatoide, la sarcoidosis, un traumatismo, una cirugía o por la extirpación del bazo.
La trombocitosis esencial o primaria no tiene una causa clara, aunque se apunta que a veces está producida una mutación genética, incluyendo mutaciones en el gen JAK2 o mutaciones en el gen calreticulina (CALR).
Síntomas de la trombocitosis
Síntomas
Las personas con trombocitosis generalmente no tienen signos o síntomas. Los signos y síntomas de la trombocitosis reactiva, si se presentan, están relacionados con la enfermedad oculta.
Las personas con trombocitosis esencial pueden tener signos y síntomas relacionados con los coágulos de sangre y las hemorragias, por ejemplo:
- Dolor de cabeza
- Mareo o aturdimiento
- Dolor en el pecho
- Debilidad
- Entumecimiento u hormigueo de las manos y los pies
Cuándo debes consultar con un médico
Puesto que es poco probable que la trombocitosis cause síntomas, quizás no sepas que tienes esta enfermedad a menos que un análisis de sangre de rutina exhiba una cantidad de plaquetas más alta de lo normal. Si esto ocurre, el médico intentará determinar la razón.
Asintomática
La trombocitosis en general es asintomática, aunque quienes padecen la enfermedad en su forma esencial o primaria pueden experimentar:
– Dolor de cabeza.
– Dolor en el pecho.
– Mareo o aturdimiento.
– Debilidad.
– Hormigueo y entumecimiento en las manos y los pies.
– Enrojecimiento y calor o ardor en las manos y los pies.
– Pérdida de visión.
– Visualización de manchas.
Diagnóstico
Análisis de sangre
La trombocitosis se suele diagnosticar en un examen rutinario de salud que incluya un análisis de sangre. El recuento plaquetario arrojará niveles muy por encima de 450.000 plaquetas por microlitro de sangre. Aparte, probablemente se detecte si el bazo está dilatado y se solicite un hemograma completo para definir si hay niveles anormales de hierro en sangre, marcadores de inflamación, marcadores de cáncer o mutaciones el gen JAK2 o en el gen CALR o en el MPL.
También se puede solicitar una punción para extraer líquido de la médula ósea para analizar.
Tratamiento y medicación
Depende de la causa
El tratamiento de la trombocitosis depende de la causa. Muchos pacientes no necesitan tratamiento aparte de un seguimiento médico periódico. A las personas que están en riesgo alto de coagulación se les puede recetar aspirina en una dosis baja. Otros medicamentos que se pueden ser administrar para reducir el número de plaquetas en sangre son hidroxiurea, interferón-alfa, o anagrelida. En algunas personas con una mutación en el gen JAK2, se pueden usar inhibidores específicos de proteína JAK2.
En casos graves, y solo en vía hospitalaria, se puede plantear la trombocitaféresis para reducir las plaquetas en la sangre rápidamente.
Prevención
Sin medidas de prevención
No se han descrito medidas de prevención frente a la trombocitosis.
